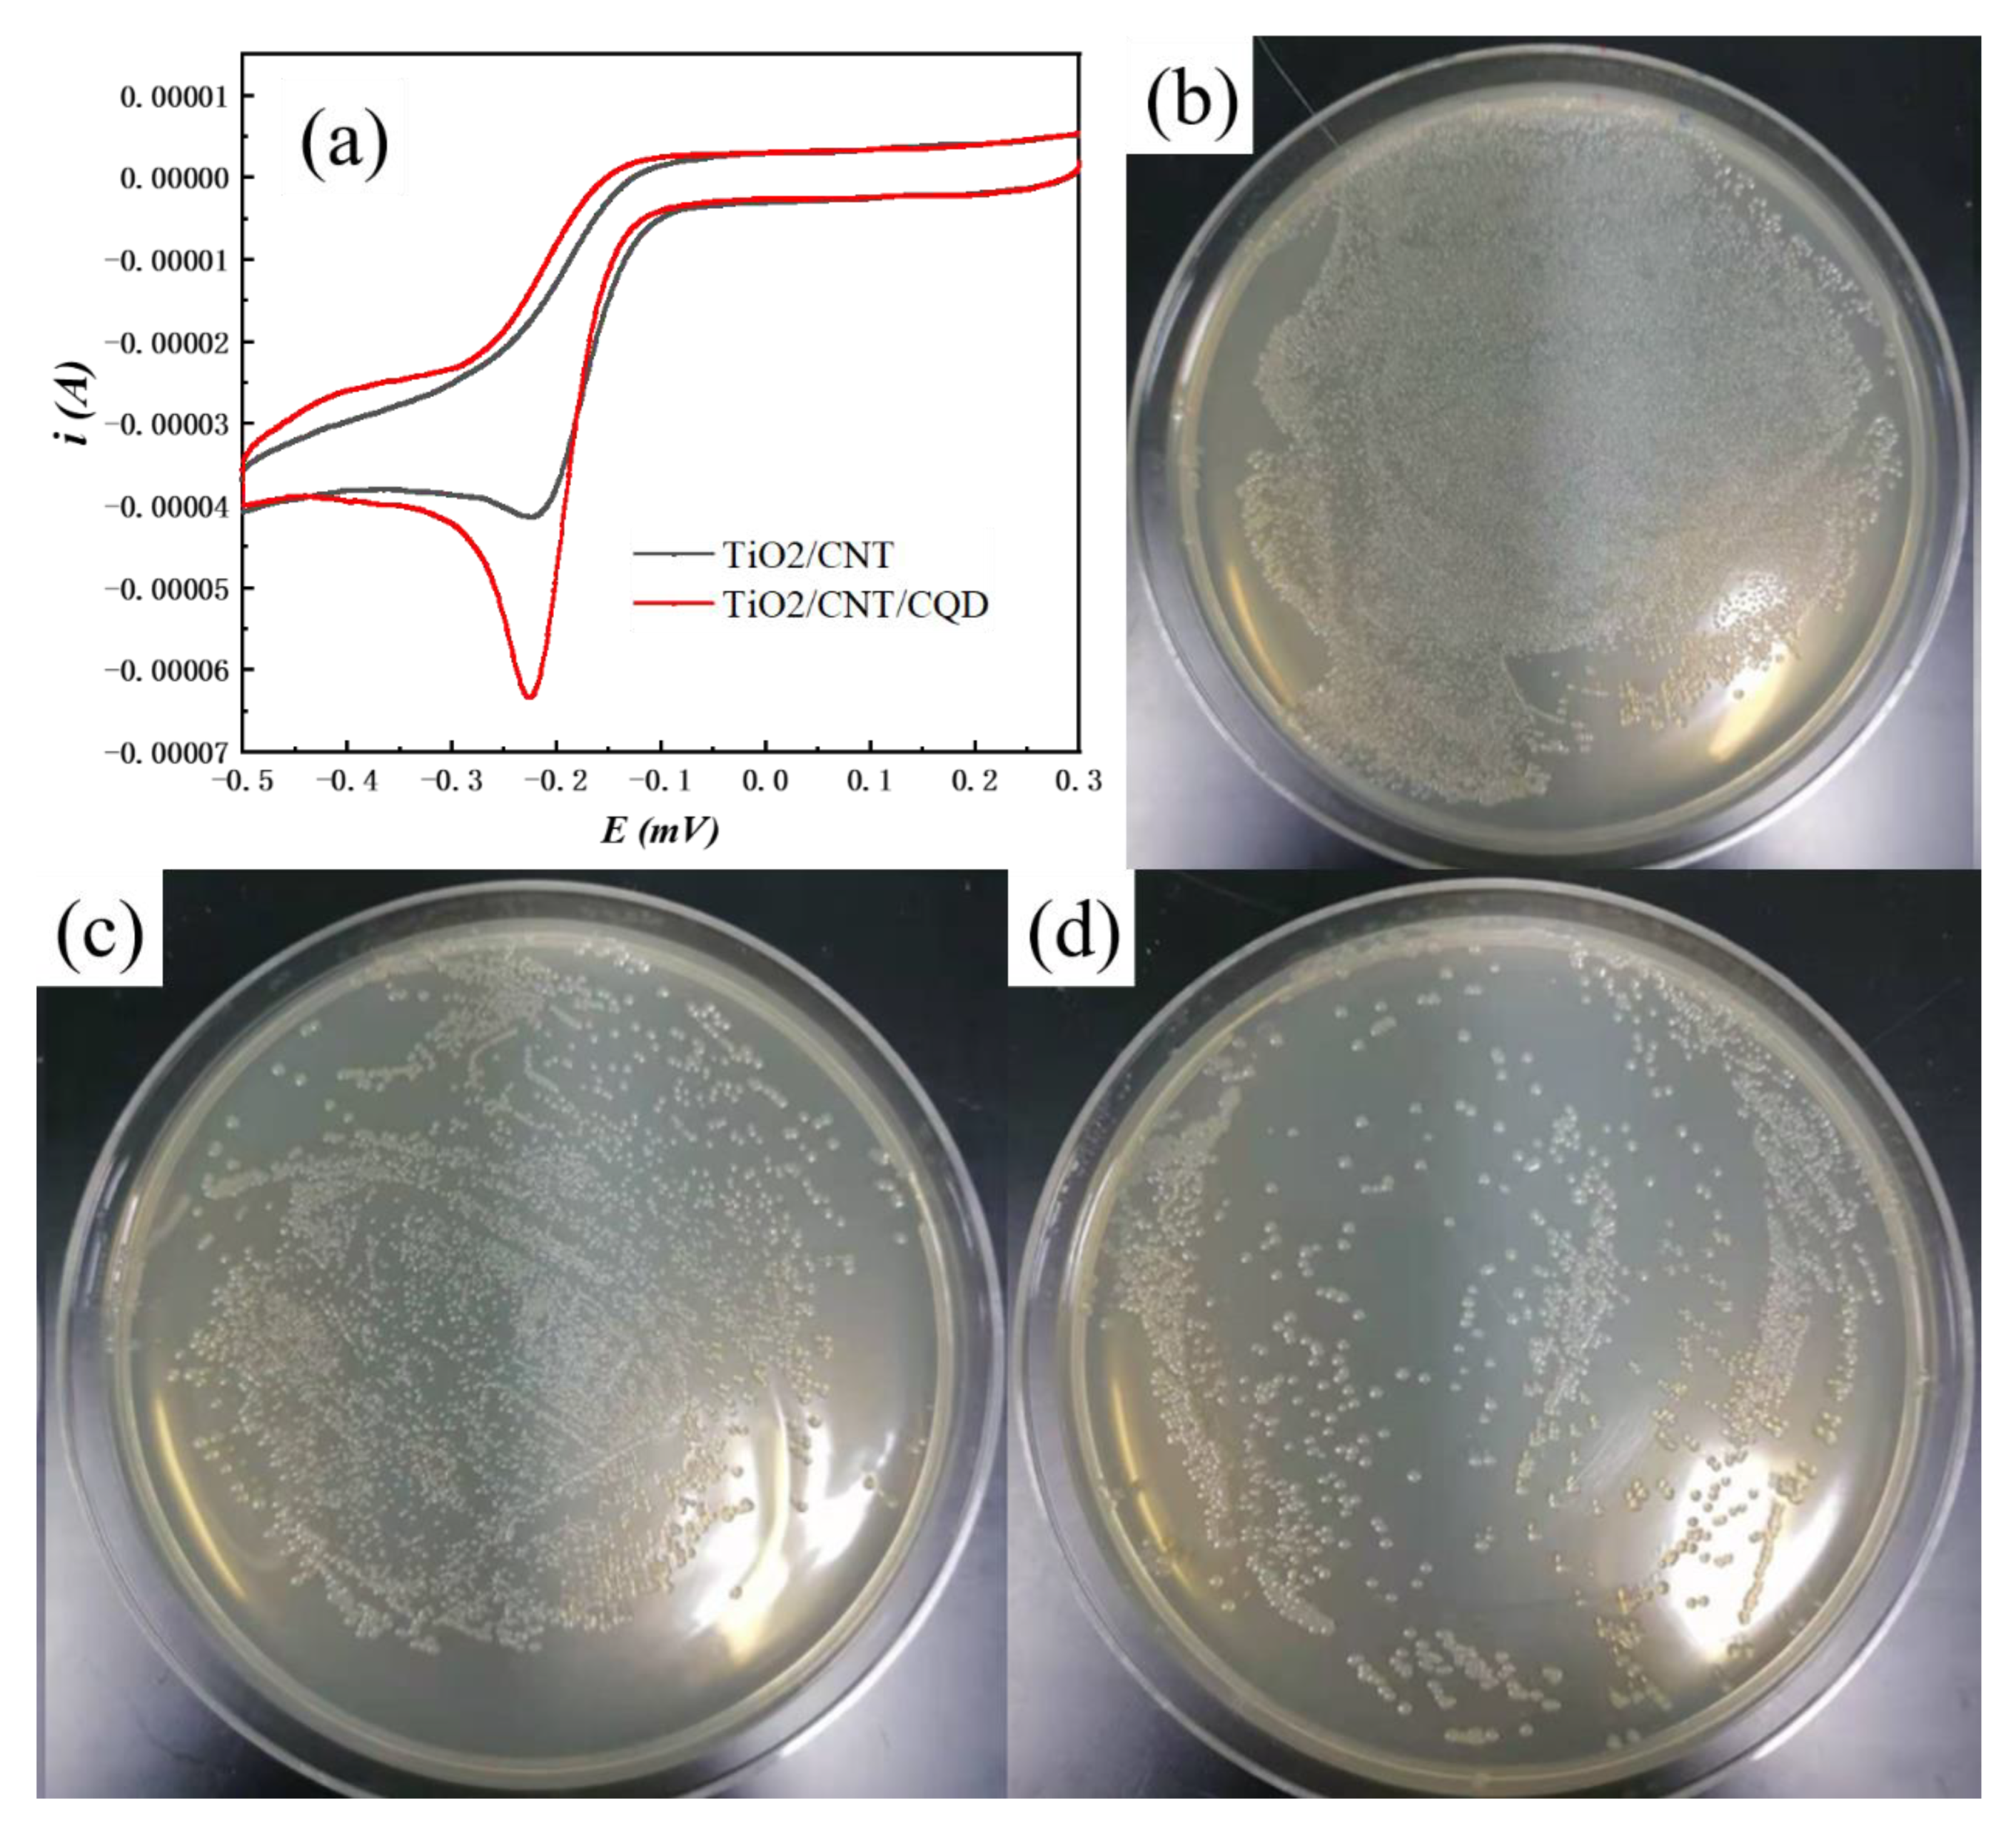
Coatings 13 00145 g005

One-Step Preparation of High Performance TiO2/CNT/CQD Nanocomposites Bactericidal Coating with Ultrasonic Radiation
Abstract
1. Introduction
2. Experimental Section
2.1. Synthesis
2.2. Characterization
2.3. Antibacterial Tests
3. Results and Discussion
4. Conclusions
- (1)
- The composites prepared exhibit a large specific surface area of 78.07 m2/g and a pore width of 10–120 nm, indicating that an ultrasonic radiation treatment contributes to forming nanocomposites with a high specific surface area.
- (2)
- Commercial P25 particles can be prepared into gel films at a low cost by sol-gel ultrasonic radiation.
- (3)
- TiO2/CNT/CQD nanocomposites prepared by doping CNT/CQD can significantly improve the visible light absorption efficiency and bactericidal efficiency.
Author Contributions
Funding
Institutional Review Board Statement
Informed Consent Statement
Data Availability Statement
Conflicts of Interest
References
- Tada, H.; Mitsui, T.; Kiyonaga, T.; Akita, T.; Tanaka, K. All-solid-state Z-scheme in CdS-Au-TiO2 three-component nanojunction system. Nat. Mater. 2006, 5, 782–786. [Google Scholar] [CrossRef] [PubMed]
- Geng, W.; Wang, L.; Yang, X.-Y. Nanocell hybrids for green chemistry. Trends Biotechnol. 2022, 40, 974–986. [Google Scholar] [CrossRef] [PubMed]
- Li, H.L.; Luo, S.W.; Zhang, L.Q.; Zhao, Z.L.; Wu, M.; Li, W.H.; Liu, F.Q. Water- and Acid-Sensitive Cu2O@Cu-MOF Nano Sustained-Release Capsules with Superior Antifouling Behaviors. ACS Appl. Mater. Interfaces 2022, 14, 1910–1920. [Google Scholar] [CrossRef] [PubMed]
- Zhao, L.; Guan, B.; Xin, Y.; Huang, X.; Liu, C.; Wu, P.; Liu, Q. A quantitative study on mechanical behavior of Mg alloys with bimodal texture components. Acta Mater. 2021, 214, 117013. [Google Scholar] [CrossRef]
- Wu, T.W.; Kong, W.H.; Zhang, Y.; Xing, Z.; Zhao, J.X.; Wang, T.; Shi, X.F.; Luo, Y.L.; Sun, X.P. Greatly Enhanced Electrocatalytic N-2 Reduction on TiO2 via V Doping. Small Methods 2019, 3, 8. [Google Scholar] [CrossRef]
- Wang, Y.X.; Rao, L.; Wang, P.F.; Shi, Z.Y.; Zhang, L.X. Photocatalytic activity of N-TiO2/O-doped N vacancy g-C3N4 and the intermediates toxicity evaluation under tetracycline hydrochloride and Cr(VI) coexistence environment. Appl. Catal. B-Environ. 2020, 262, 12. [Google Scholar] [CrossRef]
- Zhao, Z.; Lai, H.S.; Li, H.; Li, L. Preparation and Properties of Graphene Doped TiO2 Mesoporous Materials for Photocathode Protection. Int. J. Electrochem. Sci. 2021, 16, 210316. [Google Scholar] [CrossRef]
- Zhao, Z.; Jiang, X.; Li, S.; Li, L.; Feng, Z.; Lai, H. Microstructure Characterization and Battery Performance Comparison of MOF-235 and TiO2-P25 Materials. Crystals 2022, 12, 152. [Google Scholar] [CrossRef]
- Feng, Z.Y.; Hurley, B.; Zhu, M.L.; Yang, Z.; Hwang, J.; Buchheit, R. Corrosion Inhibition of AZ31 Mg Alloy by Aqueous Selenite (SeO32−). J. Electrochem. Soc. 2019, 166, C520–C529. [Google Scholar] [CrossRef]
- Tripathy, J.; Lee, K.; Schmuki, P. Tuning the Selectivity of Photocatalytic Synthetic Reactions Using Modified TiO2 Nanotubes. Angew. Chem.-Int. Ed. 2014, 53, 12605–12608. [Google Scholar] [CrossRef]
- Kong, J.J.; Rui, Z.B.; Ji, H.B. Carbon Nitride Polymer Sensitization and Nitrogen Doping of SrTiO3/TiO2 Nanotube Heterostructure toward High Visible Light Photocatalytic Performance. Ind. Eng. Chem. Res. 2017, 56, 9999–10008. [Google Scholar] [CrossRef]
- Kong, J.J.; Lai, X.D.; Rui, Z.B.; Ji, H.B.; Ji, S.F. Multichannel charge separation promoted ZnO/P25 heterojunctions for the photocatalytic oxidation of toluene. Chin. J. Catal. 2016, 37, 869–877. [Google Scholar] [CrossRef]
- Xiao, Y.-X.; Ying, J.; Chen, J.-B.; Dong, Y.; Yang, X.; Tian, G.; Wu, J.; Janiak, C.; Ozoemena, K.I.; Yang, X.-Y. Confined Ultrafine Pt in Porous Carbon Fibers and Their N-Enhanced Heavy d-π Effect. Chem. Mater. 2022, 34, 3705–3714. [Google Scholar] [CrossRef]
- Nie, X.; Wang, J.; Duan, W.; Zhao, Z.; Li, L.; Zhang, Z. One-step preparation of C-doped TiO2 nanotubes with enhanced photocatalytic activity by a water-assisted method. Crystengcomm 2021, 23, 3015–3025. [Google Scholar] [CrossRef]
- Feng, Z.; Xu, C.C.; Zhang, D.; Buchheit, R. Corrosion Protective Film Formation on Mg Alloy AZ31 by Exposure to Dilute Selenite Solutions. Materials 2021, 14, 286. [Google Scholar] [CrossRef]
- Zhao, Z.L.; Li, H.L.; Huang, L.X.; Tan, Y.; Liu, F.Q.; Li, W.H. Preparation of graphene quantum dots-doped TiO2 nanocomposites via a sol-gel method for photocathodic protection. Mol. Cryst. Liq. Cryst. 2021, 731, 80–87. [Google Scholar] [CrossRef]
- Asahi, R.; Morikawa, T.; Ohwaki, T.; Aoki, K.; Taga, Y. Visible-light photocatalysis in nitrogen-doped titanium oxides. Science 2001, 293, 269–271. [Google Scholar] [CrossRef]
- Wang, C.J.; Zhao, Y.L.; Xu, H.; Li, Y.F.; Wei, Y.C.; Liu, J.; Zhao, Z. Efficient Z-scheme photocatalysts of ultrathin g-C3N4-wrapped Au/TiO2-nanocrystals for enhanced visible-light-driven conversion of CO2 with H2O. Appl. Catal. B-Environ. 2020, 263, 13. [Google Scholar] [CrossRef]
- Dong, F.; Guo, S.; Wang, H.; Li, X.; Wu, Z. Enhancement of the Visible Light Photocatalytic Activity of C-Doped TiO2 Nanomaterials Prepared by a Green Synthetic Approach. J. Phys. Chem. C 2011, 115, 13285–13292. [Google Scholar] [CrossRef]
- Huang, W.; Wang, X.; Xue, Y.; Yang, Y.; Ao, X. Hybrid nanostructures of mixed-phase TiO2 for enhanced photoelectrochemical water splitting. RSC Adv. 2015, 5, 56098–56102. [Google Scholar] [CrossRef]
- Hwang, S.H.; Kim, C.; Jang, J. SnO2 nanoparticle embedded TiO2 nanofibers-Highly efficient photocatalyst for the degradation of rhodamine B. Catal. Commun. 2011, 12, 1037–1041. [Google Scholar] [CrossRef]
- Mei, B.; Pedersen, T.; Malacrida, P.; Bae, D.; Frydendal, R.; Hansen, O.; Vesborg, P.C.K.; Seger, B.; Chorkendorff, I. Crystalline TiO2: A Generic and Effective Electron-Conducting Protection Layer for Photoanodes and -cathodes. J. Phys. Chem. C 2015, 119, 15019–15027. [Google Scholar] [CrossRef]
- Tang, C.; Bai, H.; Liu, L.; Zan, X.; Gao, P.; Sun, D.D.; Yan, W. A green approach assembled multifunctional Ag/AgBr/TNF membrane for clean water production & disinfection of bacteria through utilizing visible light. Appl. Catal. B-Environ. 2016, 196, 57–67. [Google Scholar] [CrossRef]
- Yu, W.; Zheng, B.; Mao, K.; Jiang, J.; Luo, B.; Wu, X.; Tao, T.; Min, X.; Mi, R.; Huang, Z.; et al. Interfacial structure and photocatalytic degradation performance of graphene oxide bridged chitin-modified TiO2/carbon fiber composites. J. Clean. Prod. 2022, 361, 132261. [Google Scholar] [CrossRef]
- Wang, J.; Nie, X.; Wang, W.; Zhao, Z.; Li, L.; Zhang, Z. Single-layer graphene-TiO2 nanotubes array heterojunction as photoanode to enhance the photoelectric of DSSCs. Optik 2021, 242, 167245. [Google Scholar] [CrossRef]
- Feng, Z.; Li, J.; Ma, J.; Su, Y.; Zheng, X.; Mao, Y.; Zhao, Z. EBSD Characterization of 7075 Aluminum Alloy and Its Corrosion Behaviors in SRB Marine Environment. J. Mar. Sci. Eng. 2022, 10, 740. [Google Scholar] [CrossRef]
- Ying, J.; Janiak, C.; Xiao, Y.-X.; Wei, H.; Yang, X.-Y.; Su, B.-L. Shape-Controlled Surface-Coating to Pd@Mesoporous Silica Core–Shell Nanocatalysts with High Catalytic Activity and Stability. Chem. Asian J. 2018, 13, 31–34. [Google Scholar] [CrossRef]
- Shen, L.; Ying, J.; Tian, G.; Jia, M.; Yang, X.-Y. Ultralong PtPd Alloyed Nanowires Anchored on Graphene for Efficient Methanol Oxidation Reaction. Chem.—Asian J. 2021, 16, 1130–1137. [Google Scholar] [CrossRef]
- Xiao, Y.-X.; Ying, J.; Tian, G.; Tao, Y.; Wei, H.; Fan, S.-Y.; Sun, Z.-H.; Zou, W.-J.; Hu, J.; Chang, G.-G.; et al. Highly dispersed PtPd on graphitic nanofibers and its heavy d-π effect. Appl. Catal. B Environ. 2019, 259, 118080. [Google Scholar] [CrossRef]
- Xiao, Y.X.; Ying, J.; Tian, G.; Zhang, X.Q.; Janiak, C.; Ozoemena, K.I.; Yang, X.Y. PtPd hollow nanocubes with enhanced alloy effect and active facets for efficient methanol oxidation reaction. Chem. Commun. 2021, 57, 986–989. [Google Scholar] [CrossRef]
- Li, J.; Li, T.; Zeng, Y.; Chen, C.; Guo, H.; Lei, B.; Zhang, P.; Feng, Z.; Meng, G. A novel sol-gel coating via catechol/lysine polymerization for long-lasting corrosion protection of Mg alloy AZ31. Colloids Surf. A Physicochem. Eng. Asp. 2023, 656, 130361. [Google Scholar] [CrossRef]
- Zheng, H.Y.; Guo, Y.C.; Shen, F.M. Production of titanium powder by metallothermic reduction of TiO2 in cold pressed pellets. J. Cent. South Univ. 2021, 28, 48–57. [Google Scholar] [CrossRef]
- Xue, S.G.; Tang, L.; Tang, T.; Zhang, F.; Lyu, H.G.; Liu, H.Y.; Jiang, J.; Huang, Y.H. Identifying the active sites in C-N codoped TiO2 electrode for electrocatalytic water oxidation to produce H2O2. J. Cent. South Univ. 2022, 29, 3016–3029. [Google Scholar] [CrossRef]
- Fan, B.Y.; Liu, H.B.; Wang, Z.H.; Zhao, Y.W.; Yang, S.; Lyu, S.Y.; Xing, A.; Zhang, J.; Li, H.; Liu, X.Y. Ferroelectric polarization-enhanced photocatalytic performance of heterostructured BaTiO3@TiO2 via interface engineering. J. Cent. South Univ. 2021, 28, 3778–3789. [Google Scholar] [CrossRef]
- Nong, S.; Dong, W.; Yin, J.; Dong, B.; Lu, Y.; Yuan, X.; Wang, X.; Bu, K.; Chen, M.; Jiang, S.; et al. Well-Dispersed Ruthenium in Mesoporous Crystal TiO2 as an Advanced Electrocatalyst for Hydrogen Evolution Reaction. J. Am. Chem. Soc. 2018, 140, 5719–5727. [Google Scholar] [CrossRef]
- Xiao, Y.X.; Ying, J.; Tian, G.; Yang, X.; Zhang, Y.X.; Chen, J.B.; Wang, Y.; Symes, M.D.; Ozoemena, K.I.; Wu, J.; et al. Hierarchically Fractal PtPdCu Sponges and their Directed Mass- and Electron-Transfer Effects. Nano Lett. 2021, 21, 7870–7878. [Google Scholar] [CrossRef]
- Shen, L.; Ying, J.; Ozoemena, K.I.; Janiak, C.; Yang, X.-Y. Confinement Effects in Individual Carbon Encapsulated Nonprecious Metal-Based Electrocatalysts. Adv. Funct. Mater. 2022, 32, 2110851. [Google Scholar] [CrossRef]
- Zhao, Z.; Liu, X.; Li, S.; Mao, Y.; Feng, Z.; Ke, W.; Liu, F. Study on Strengthening and Toughening of Mechanical Properties of Mg-Li Alloy by Adding Non-Rare-Earth Elements Al and Si. JOM 2022, 74, 2554–2565. [Google Scholar] [CrossRef]
- Bai, C.; Xiang, J.; Zhao, Z.; Luo, S.; Li, L. Improvement of hydrogen production performance by in situ doping of carbon nanotubes into TiO2 materials. J. Nanopart. Res. 2022, 24, 61. [Google Scholar] [CrossRef]
- Yang, F.; Wen, L.Y.; Peng, Q.; Zhao, Y.; Xu, J.; Hu, M.L.; Zhang, S.F.; Yang, Z.Q. Prediction of structural and electronic properties of Cl-2 adsorbed on TiO2(100) surface with C or CO in fluidized chlorination process: A first-principles study. J. Cent. South Univ. 2021, 28, 29–38. [Google Scholar] [CrossRef]
- Nie, X.J.; Yin, S.Q.; Duan, W.C.; Zhao, Z.L.; Li, L.; Zhang, Z.Q. Recent Progress in Anodic Oxidation of TiO2 Nanotubes and Enhanced Photocatalytic Performance: A Short Review. Nano 2021, 16, 2130002. [Google Scholar] [CrossRef]
- Zhang, R.; Wu, H.; Lin, D.D.; Pan, W. Preparation of Necklace-Structured TiO2/SnO2 Hybrid Nanofibers and Their Photocatalytic Activity. J. Am. Ceram. Soc. 2009, 92, 2463–2466. [Google Scholar] [CrossRef]
- Zhao, J.; Zhang, J.L.; Wang, L.; Lyu, S.S.; Ye, W.L.; Xu, B.B.; Qiu, H.; Chen, L.X.; Gu, J.W. Fabrication and investigation on ternary heterogeneous MWCNT@TiO2-C fillers and their silicone rubber wave-absorbing composites. Compos. Pt. A-Appl. Sci. Manuf. 2020, 129, 8. [Google Scholar] [CrossRef]
- Hu, G.; Xiao, Y.; Ying, J. Nano-SiO2 and Silane Coupling Agent Co-Decorated Graphene Oxides with Enhanced Anti-Corrosion Performance of Epoxy Composite Coatings. Int. J. Mol. Sci. 2021, 22, 11087. [Google Scholar] [CrossRef]
- Zheng, J.Y.; Lyu, Y.H.; Wang, R.L.; Xie, C.; Zhou, H.J.; Jiang, S.P.; Wang, S.Y. Crystalline TiO2 protective layer with graded oxygen defects for efficient and stable silicon-based photocathode. Nat. Commun. 2018, 9, 3572. [Google Scholar] [CrossRef]
- Zeng, L.; Cui, H.; Peng, H.; Sun, X.; Liu, Y.; Huang, J.; Lin, X.; Guo, H.; Li, W.-H. Oleophobic interaction mediated slippery organogels with ameliorated mechanical performance and satisfactory fouling-resistance. J. Mater. Sci. Technol. 2022, 121, 227–235. [Google Scholar] [CrossRef]
- Liu, Y.; Cui, H.; Wang, X.; Ouyang, G.; Guo, H. Hydrogels with Reversible Heat-Trained Toughness for Convenient Manufacture. Adv. Mater. Technol. 2022, 110, 2201346. [Google Scholar] [CrossRef]
- Zeng, L.; Lin, X.; Li, P.; Liu, F.-Q.; Guo, H.; Li, W.-H. Recent advances of organogels: From fabrications and functions to applications. Prog. Org. Coat. 2021, 159, 106417. [Google Scholar] [CrossRef]
- Zhou, W.; Sun, F.; Pan, K.; Tian, G.; Jiang, B.; Ren, Z.; Tian, C.; Fu, H. Well-Ordered Large-Pore Mesoporous Anatase TiO2 with Remarkably High Thermal Stability and Improved Crystallinity: Preparation, Characterization, and Photocatalytic Performance. Adv. Funct. Mater. 2011, 21, 1922–1930. [Google Scholar] [CrossRef]

Disclaimer/Publisher’s Note: The statements, opinions and data contained in all publications are solely those of the individual author(s) and contributor(s) and not of MDPI and/or the editor(s). MDPI and/or the editor(s) disclaim responsibility for any injury to people or property resulting from any ideas, methods, instructions or products referred to in the content. |
© 2023 by the authors. Licensee MDPI, Basel, Switzerland. This article is an open access article distributed under the terms and conditions of the Creative Commons Attribution (CC BY) license (https://creativecommons.org/licenses/by/4.0/).
Share and Cite
Xiang, J.; Wang, S.; Cao, Y.; Fang, L.; Ke, W.; Guo, H.; Duan, B.; Yu, W.; Li, L.; Zhao, Z. One-Step Preparation of High Performance TiO2/CNT/CQD Nanocomposites Bactericidal Coating with Ultrasonic Radiation. Coatings 2023, 13, 145. https://doi.org/10.3390/coatings13010145
Xiang J, Wang S, Cao Y, Fang L, Ke W, Guo H, Duan B, Yu W, Li L, Zhao Z. One-Step Preparation of High Performance TiO2/CNT/CQD Nanocomposites Bactericidal Coating with Ultrasonic Radiation. Coatings. 2023; 13(1):145. https://doi.org/10.3390/coatings13010145
Chicago/Turabian StyleXiang, Jin, Shuchang Wang, Yuanxin Cao, Lining Fang, Wei Ke, Hui Guo, Baoyu Duan, Wenhe Yu, Liang Li, and Zilong Zhao. 2023. "One-Step Preparation of High Performance TiO2/CNT/CQD Nanocomposites Bactericidal Coating with Ultrasonic Radiation" Coatings 13, no. 1: 145. https://doi.org/10.3390/coatings13010145
APA StyleXiang, J., Wang, S., Cao, Y., Fang, L., Ke, W., Guo, H., Duan, B., Yu, W., Li, L., & Zhao, Z. (2023). One-Step Preparation of High Performance TiO2/CNT/CQD Nanocomposites Bactericidal Coating with Ultrasonic Radiation. Coatings, 13(1), 145. https://doi.org/10.3390/coatings13010145

